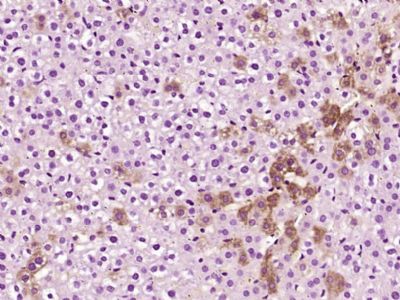
alpha 1 Antitrypsin antibody

相关产品推荐更多 >
万千商家帮你免费找货
0 人在求购买到急需产品
- 详细信息
- 技术资料
- 供应商:
上海康朗生物科技有限公司
- 库存:
大量
- 目录编号:
kl-0096R
- 克隆性:
多克隆
- 抗原来源:
Rabbit
- 保质期:
12个月
- 抗体英文名:
alpha 1 Antitrypsin antibody
- 抗体名:
alpha 1 Antitrypsin antibody
- 宿主:
Rabbit
- 适应物种:
Human, Mouse, Rat, Dog, Pig, Cow,
- 免疫原:
KLH conjugated synthetic peptide derived from human Nestin:801-900/1621
- 亚型:
IgG
- 形态:
冻干粉或液体
- 应用范围:
ELISA=1:500-1000 IHC-P=1:400-800 IHC-F=1:400-800 IF=1:100-500
- 浓度:
1mg/ml
- 保存条件:
-20 °C
- 规格:
50ul 100ul 200ul
alpha 1 Antitrypsin antibody
| 中文名称 | α-1抗胰蛋白酶抗体 |
| 别 名 | A1-Antitrypsin; Tryptase; Alpha-1-Antitrypsin; alpha 1-antitrypsin; A1A; A1AT; AAT; Alpha 1 antiproteinase; Alpha 1 protease inhibitor; alpha-1-AT; alpha1 PI; alpha1 proteinase inhibitor; Clade A (alpha 1 antiproteinase antitrypsin) member 1; MGC23330; MGC9222; PI; PI; PRO2275; Protease inhibitor 1 (anti elastase); Serpin A1; Serpin peptidase inhibitor clade A (alpha 1 antiproteinase antitrypsin) member 1; SerpinA1; A1AT_HUMAN; Alpha-1-antitrypsin; Alpha-1 protease inhibitor; Alpha-1-antiproteinase; Serpin A1. |
| 规格价格 | 50ul/780元 购买 100ul/1380元 购买 200ul/2200元 购买 大包装/询价 |
| 说 明 书 | 50ul 100ul 200ul |
| 研究领域 | 心血管 免疫学 新陈代谢 |
| 抗体来源 | Rabbit |
| 克隆类型 | Polyclonal |
| 交叉反应 | Human, Mouse, Rat, Dog, Pig, Cow, |
| 产品应用 | ELISA=1:500-1000 IHC-P=1:400-800 (石蜡切片需做抗原修复) not yet tested in other applications. optimal dilutions/concentrations should be determined by the end user. |
| 分 子 量 | 44kDa |
| 细胞定位 | 细胞外基质 分泌型蛋白 |
| 性 状 | Lyophilized or Liquid |
| 浓 度 | 1mg/ml |
| 免 疫 原 | KLH conjugated synthetic peptide derived from human alpha 1 Antitrypsin:101-200/418 |
| 亚 型 | IgG |
| 纯化方法 | affinity purified by Protein A |
| 储 存 液 | 0.01M TBS(pH7.4) with 1% BSA, 0.03% Proclin300 and 50% Glycerol. |
| 保存条件 | Store at -20 °C for one year. Avoid repeated freeze/thaw cycles. The lyophilized antibody is stable at room temperature for at least one month and for greater than a year when kept at -20°C. When reconstituted in sterile pH 7.4 0.01M PBS or diluent of antibody the antibody is stable for at least two weeks at 2-4 °C. |
| PubMed | PubMed |
| 产品介绍 | background: Alpha-1-antitrypsin is a protease inhibitor, deficiency of which is associated with emphysema and liver disease. The protein is encoded by a gene (PI) located on the distal long arm of chromosome 14. Function: Inhibitor of serine proteases. Its primary target is elastase, but it also has a moderate affinity for plasmin and thrombin. Irreversibly inhibits trypsin, chymotrypsin and plasminogen activator. The aberrant form inhibits insulin-induced NO synthesis in platelets, decreases coagulation time and has proteolytic activity against insulin and plasmin. Short peptide from AAT (SPAAT) is a reversible chymotrypsin inhibitor. It also inhibits elastase, but not trypsin. Its major physiological function is the protection of the lower respiratory tract against proteolytic destruction by human leukocyte elastase (HLE). Subcellular Location: Secreted. Short peptide from AAT: Secreted, extracellular space, extracellular matrix. Tissue Specificity: Plasma. Post-translational modifications: N-glycosylated. Differential glycosylation produces a number of isoforms. N-linked glycan at Asn-107 is alternatively di-antennary, tri-antennary or tetra-antennary. The glycan at Asn-70 is di-antennary with trace amounts of tri-antennary. Glycan at Asn-271 is exclusively di-antennary. Structure of glycans at Asn-70 and Asn-271 is Hex5HexNAc4. The structure of the antennae is Neu5Ac(alpha1-6)Gal(beta1-4)GlcNAc attached to the core structure Man(alpha1-6)[Man(alpha1-3)]Man(beta1-4)GlcNAc(beta1-4)GlcNAc. Some antennae are fucosylated, which forms a Lewis-X determinant. Proteolytic processing may yield the truncated form that ranges from Asp-30 to Lys-418. DISEASE: Defects in SERPINA1 are the cause of alpha-1-antitrypsin deficiency (A1ATD) [MIM:613490]. A disorder whose most common manifestation is emphysema, which becomes evident by the third to fourth decade. A less common manifestation of the deficiency is liver disease, which occurs in children and adults, and may result in cirrhosis and liver failure. Environmental factors, particularly cigarette smoking, greatly increase the risk of emphysema at an earlier age. Similarity: Belongs to the serpin family. SWISS: P01009 Gene ID: 5265 Database links: Entrez Gene: 5265 Human Entrez Gene: 24648 Rat Omim: 107400 Human SwissProt: P01009 Human SwissProt: P07758 Mouse SwissProt: P17475 Rat Unigene: 525557 Human Important Note: This product as supplied is intended for research use only, not for use in human, therapeutic or diagnostic applications. α1-抗胰蛋白酶(A1AT)缺乏是最常见的遗传代谢病,能引起肺和肝的损伤。α1抗胰蛋白酶为呼吸系统的非特异性可溶因子,与呼吸道抵抗力关系密切,它可抑制多种酶的活性,包括细菌的酶,以及中性白细胞溶酶体分泌的蛋白酶、弹性蛋白酶、胶原酶、纤维蛋白溶酶和凝血酶。α1抗胰蛋白酶的缺乏与慢性阻塞性肺病的形成关系密切,因为它的缺乏,不能及时控制感染和炎症产生的多种蛋白酶,而造成肺组织破坏。 α1-抗胰蛋白酶由肝细胞产生,是一种分子量为45-56kDa的糖蛋白,它能抑制蛋白酶、弹性蛋白酶、胶原酶等多种水解酶的活性。 AAT也是一种糖蛋白,主要用于遗传性AAT缺乏症和良性恶性肝肿瘤、内胚窦瘤、组织细胞性淋巴瘤以及胰腺癌、胃癌、结肠癌等各种肿瘤的研究。此抗体与大、小鼠、狗和猪有交叉反应。 |
| 产品图片 | ![]() Paraformaldehyde-fixed, paraffin embedded (Human liver carcinoma); Antigen retrieval by boiling in sodium citrate buffer (pH6.0) for 15min; Block endogenous peroxidase by 3% hydrogen peroxide for 20 minutes; Blocking buffer (normal goat serum) at 37°C for 30min; Antibody incubation with (alpha 1 Antitrypsin) Polyclonal Antibody, Unconjugated (bs-0096R) at 1:400 overnight at 4°C, followed by operating according to SP Kit(Rabbit) (sp-0023) instructionsand DAB staining. ![]() Paraformaldehyde-fixed, paraffin embedded (Rat liver); Antigen retrieval by boiling in sodium citrate buffer (pH6.0) for 15min; Block endogenous peroxidase by 3% hydrogen peroxide for 20 minutes; Blocking buffer (normal goat serum) at 37°C for 30min; Antibody incubation with (alpha 1 Antitrypsin) Polyclonal Antibody, Unconjugated (bs-0096R) at 1:400 overnight at 4°C, followed by operating according to SP Kit(Rabbit) (sp-0023) instructionsand DAB staining. |
风险提示:丁香通仅作为第三方平台,为商家信息发布提供平台空间。用户咨询产品时请注意保护个人信息及财产安全,合理判断,谨慎选购商品,商家和用户对交易行为负责。对于医疗器械类产品,请先查证核实企业经营资质和医疗器械产品注册证情况。
技术资料暂无技术资料 索取技术资料
alpha 1 Antitrypsin antibody
¥780 - 2200